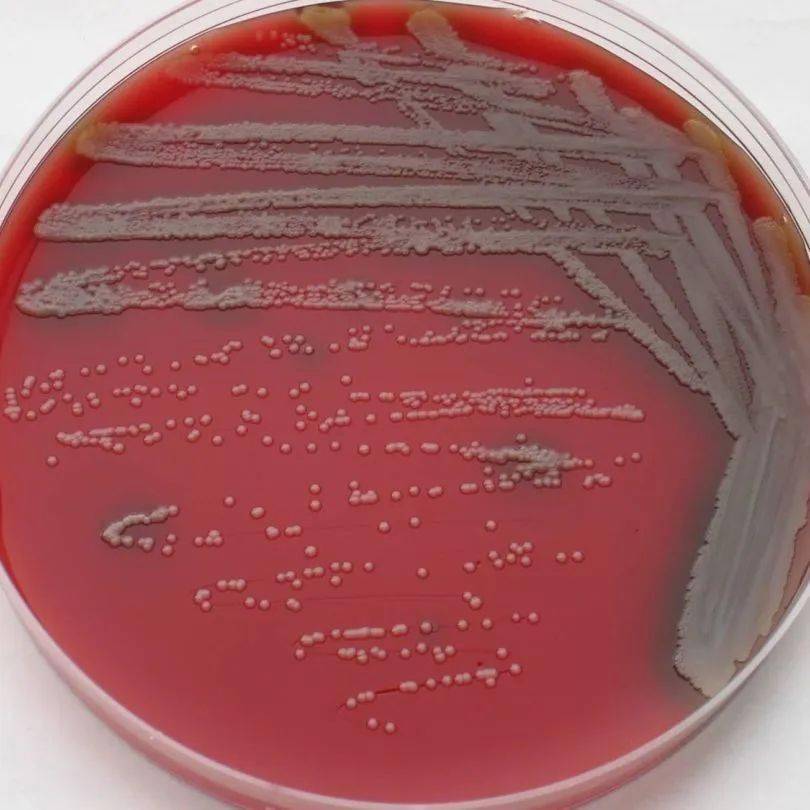
大多数细菌和霉菌已经停止生长,但是奥斯陆莫拉菌仍然能够活跃地蹦踧

奥斯陆莫拉菌

大多数细菌和霉菌已经停止生长,但是奥斯陆莫拉菌仍然能够活跃地蹦踧
图片尺寸810x810
视频已打包,欢迎围观!
图片尺寸1024x768
科学家在美国俄勒冈州东部森林中发现,蜜环菌(honey mushroom)的
图片尺寸1800x1350
(一)卡他莫拉菌
图片尺寸960x540
衣服上的迷之臭味,你遇到过吗?
图片尺寸660x370
图十 l型奥斯陆莫拉菌(革兰染色,x1000)结果显示它是对万古霉素敏感
图片尺寸1080x1439
3 卡他莫拉菌(阿莫西林/克拉维酸 敏感):与正常形态相比,菌体大部分
图片尺寸600x800
这些细菌包括不动杆菌,莫拉氏菌,金黄杆菌,霉菌等等,其中有数种还是致
图片尺寸640x320
卡他莫拉菌的分离与鉴定
图片尺寸1598x1200
lactobacillus casei
图片尺寸1500x843
卡他莫拉菌的分离与鉴定
图片尺寸1025x769
卡他莫拉菌是一种会附着在衣物上的细菌,它不止会产生令你想呕吐的
图片尺寸780x585
流感嗜血杆菌显微镜下形态图片来源:《实用临床微生物学检验与图谱
图片尺寸1080x395
肺炎链球菌,流感嗜血杆菌和卡他莫拉菌
图片尺寸473x355
卡他莫拉菌
图片尺寸220x165
卡他莫拉菌的分离与鉴定
图片尺寸645x480
但与涂片镜检结果一致(肺炎链球菌,流感杆菌,卡他莫拉菌);③入院3天内
图片尺寸640x427
由肺炎链球菌,流感嗜血杆菌,副流感嗜血杆菌,卡他莫拉菌,金黄色葡萄
图片尺寸1000x1000
卡他莫拉菌肺炎
图片尺寸219x220
monopterus albus
图片尺寸630x422